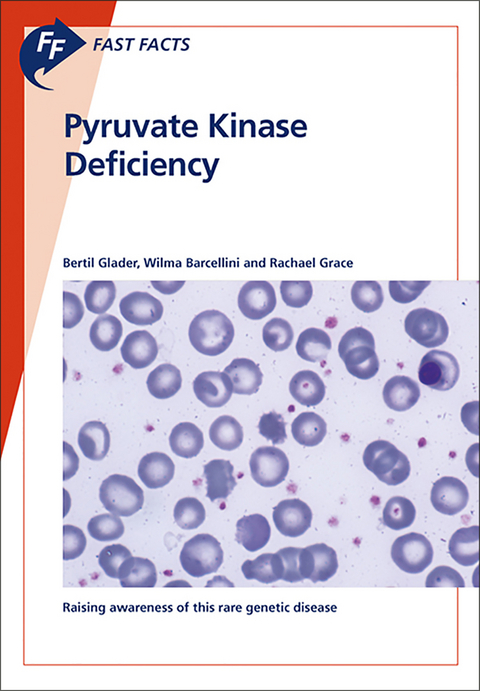
Fast Facts: Pyruvate Kinase Deficiency - Bertil Glader, Wilma Barcellini, Rachael Grace

Fast Facts: Pyruvate Kinase Deficiency
Seiten
2018
S. Karger Publishers Ltd (Verlag)
978-1-910797-88-4 (ISBN)
S. Karger Publishers Ltd (Verlag)
978-1-910797-88-4 (ISBN)
- Keine Verlagsinformationen verfügbar
- Artikel merken
Written by experts in the field, Fast Facts: Pyruvate Kinase Deficiency provides a comprehensive introduction to this rare genetic blood disorder
You may be unfamiliar with pyruvate kinase (PK) deficiency. It is a rare inherited enzyme disorder that affects the glycolytic pathway used by red blood cells to generate energy, manifesting as hemolytic anemia. The symptoms vary greatly between individuals, making diagnosis difficult, and management primarily comprises supportive treatments.
Written by experts in the field, Fast Facts: Pyruvate Kinase Deficiency provides a comprehensive introduction to the condition, including details of:
* the underlying defect
* its mode of inheritance, and the relationship between genotype and phenotype
* how the condition manifests
* the fundamentals of diagnosis and how to differentiate it from a heterogeneous group of hemolytic disorders
* monitoring and managing the complications that may arise.
Fast Facts: Pyruvate Kinase Deficiency will be of interest to primary care providers, hematologists, oncologists, pediatricians, internal medicine specialists, hematology nurses and medical students; indeed, anyone who wishes to learn more about this rare genetic blood disorder.
You may be unfamiliar with pyruvate kinase (PK) deficiency. It is a rare inherited enzyme disorder that affects the glycolytic pathway used by red blood cells to generate energy, manifesting as hemolytic anemia. The symptoms vary greatly between individuals, making diagnosis difficult, and management primarily comprises supportive treatments.
Written by experts in the field, Fast Facts: Pyruvate Kinase Deficiency provides a comprehensive introduction to the condition, including details of:
* the underlying defect
* its mode of inheritance, and the relationship between genotype and phenotype
* how the condition manifests
* the fundamentals of diagnosis and how to differentiate it from a heterogeneous group of hemolytic disorders
* monitoring and managing the complications that may arise.
Fast Facts: Pyruvate Kinase Deficiency will be of interest to primary care providers, hematologists, oncologists, pediatricians, internal medicine specialists, hematology nurses and medical students; indeed, anyone who wishes to learn more about this rare genetic blood disorder.
| Erscheinungsdatum | 26.06.2018 |
|---|---|
| Zusatzinfo | 11 Illustrations |
| Verlagsort | Abingdon |
| Sprache | englisch |
| Maße | 150 x 208 mm |
| Themenwelt | Medizinische Fachgebiete ► Innere Medizin ► Hämatologie |
| Medizin / Pharmazie ► Medizinische Fachgebiete ► Onkologie | |
| ISBN-10 | 1-910797-88-X / 191079788X |
| ISBN-13 | 978-1-910797-88-4 / 9781910797884 |
| Zustand | Neuware |
| Informationen gemäß Produktsicherheitsverordnung (GPSR) | |
| Haben Sie eine Frage zum Produkt? |
Mehr entdecken
aus dem Bereich
aus dem Bereich
Buch | Softcover (2024)
Urban & Fischer in Elsevier (Verlag)
CHF 73,00
Wie Leukämien und Lymphome bei Kindern heilbar wurden
Buch | Softcover (2025)
Lehmanns Media (Verlag)
CHF 41,90